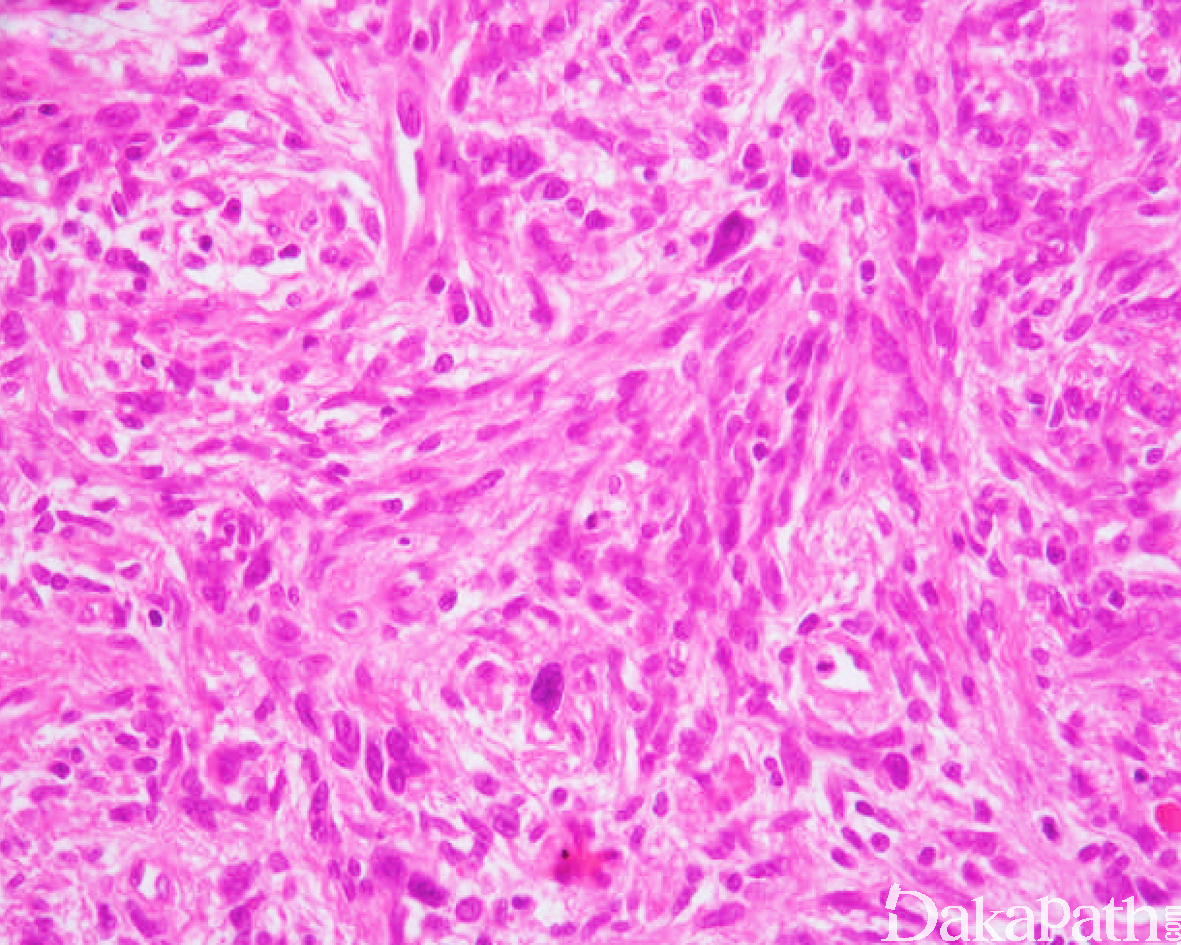

前列腺间质肉瘤
Prostate Stromal Sarcoma
概述:
来源于前列腺特异性间质的肉瘤
发病部位: 前列腺
诊断要点:
前列腺间质肉瘤少见,发病年龄年轻,半数以上的间质肉瘤发病于 50 岁之前。
临床表现与 STUMP 相似包括尿潴留,血精,异常的直肠指诊或影像学可探测的前列腺肿块形成。间质肉瘤可能伴随 STUMP 发生,或者是先前的 STUMP 恶性转化的结局;另外一些病例一开始发病即为间质肉瘤。
大体上,间质肉瘤表现为实性或部分囊性的界限欠清的前列腺实质性肿块,囊性变对应于相应的叶状型组织学构型;肿瘤直径 2-18cm 不等;切面灰白,灰黄,与 STUMP 相比,出血坏死较常见。
组织学上,间质肉瘤表现为间质过度增生伴或不伴有内陷的良性腺体,细胞密度增加,瘤细胞具有明显的多形性和活跃的核分裂活性。组织构型上,双向型叶状肿瘤最为常见,表现为肉瘤样的间质伴有内陷的良性前列腺腺体形成类似于乳腺叶状肿瘤的分叶状结构,其它组织学构型包括席纹状,纤维肉瘤样以及无结构的排列方式,偶尔肿瘤细胞可表现为上皮样或横纹肌样细胞表型。
在实践诊断过程中,依据肿瘤细胞的异性型程度,核分裂像的多少以及有无肿瘤性坏死,间质肉瘤通常分为高级别和低级别间质肉瘤,但是目前还没有严格界定低级别和高级别间质肉瘤的具体量化标准,一般来说高级别肉瘤具有中-重度的细胞异型性,明显升高的核分裂像和存在肿瘤性坏死。
免疫组织化学染色:
肿瘤细胞表达 Vimentin, CD34 以及 PR, 不同程度表达 SMA, desmin 以及 MSA,一般不表达 ER,S100,c-kit。叶状型肿瘤中的上皮成分表达 PSA。
分子标记:
无
鉴别诊断:
前列腺间质肉瘤的鉴别诊断主要包括 STUMP,肉瘤样前列腺癌,以及累及前列腺的其它梭形细胞肿瘤如平滑肌肉瘤,横纹肌肉瘤,胃肠道间质肿瘤,孤立性纤维性肿瘤和滑膜肉瘤等。
低级别间质肉瘤需要与 STUMP 鉴别,区分两者最重要的组织学特征是前者存在核分裂像,特别是非典型核分裂像以及存在前列腺外的扩散;虽然间质肉瘤核增殖指数一般较 STUMP 高,但是两者可存在重叠,因此 Ki67 免疫标记不能作为鉴别两者的指标。
前列腺肉瘤样癌除了梭形细胞肿瘤成分之外,同时还混有癌性腺样成分,而且梭形细胞成分通常至少局灶性表达广谱角蛋白。
前列腺平滑肌肉瘤常表现为明显的束状结构和嗜酸性肿瘤胞浆,免疫组化染色可表达 PR, 但与间质肉瘤不同,平滑肌肿瘤强表达 SMA 和 desmin, 较少表达 CD34。
前列腺横纹肌肉瘤主要发生在年轻人,免疫组化除了表达广谱肌源性标记物之外,还表达 myogenin 和 myoD1。
胃肠道间质肿瘤罕见的情况下可累及前列腺,免疫组化表达 c-kit 和 DOG1 可用于证实诊断。
孤立性纤维性肿瘤常见绳索样胶原纤维沉积,鹿角状血管以及血管周玻璃样变性,免疫组化染色除了表达 CD34 之外,还表达 Bcl-2 和 CD99。
前列腺滑膜肉瘤罕见,组织学结构多样,可表现为腺样和梭形细胞的双向分化,与前列腺间质肉瘤不同,滑膜肉瘤的腺样成分不表达 PSA, 梭形细胞一般不表达 CD34,分子遗传学检测 SYT-SSX 融合基因可明确诊断。
预后:
前列腺间质肉瘤预后差,具有较高的复发率以及局部浸润和远处转移的潜能。约 65%的叶状型间质肉瘤出现复发,低级别间质肉瘤复发可转化为高级别间质肉瘤,局部侵袭性生长包括累及精囊腺,膀胱,结肠,盆壁以及腹膜等
治疗:
根治前列腺切除伴术后辅助治疗
病例报道:
Sarcomatoid carcinoma of theprostate: ductal adenocarcinoma andstromal sarcoma-like appearance: a rare association.
参考文献:
[1] Herawi M, Epstein JI. Specialized stromal tumors of the prostate: a clinicopathologic study of 50 cases. Am J Surg Pathol, 2006, 30(6): 694-704. [2] Hansel DE, Herawi M, Montgomery E, et al. Spindle cell lesions of the adult prostate. Mod Pathol, 2007, 20(1): 148-158.
← 前列腺胃肠道间质肿瘤 前列腺横纹肌样瘤 →